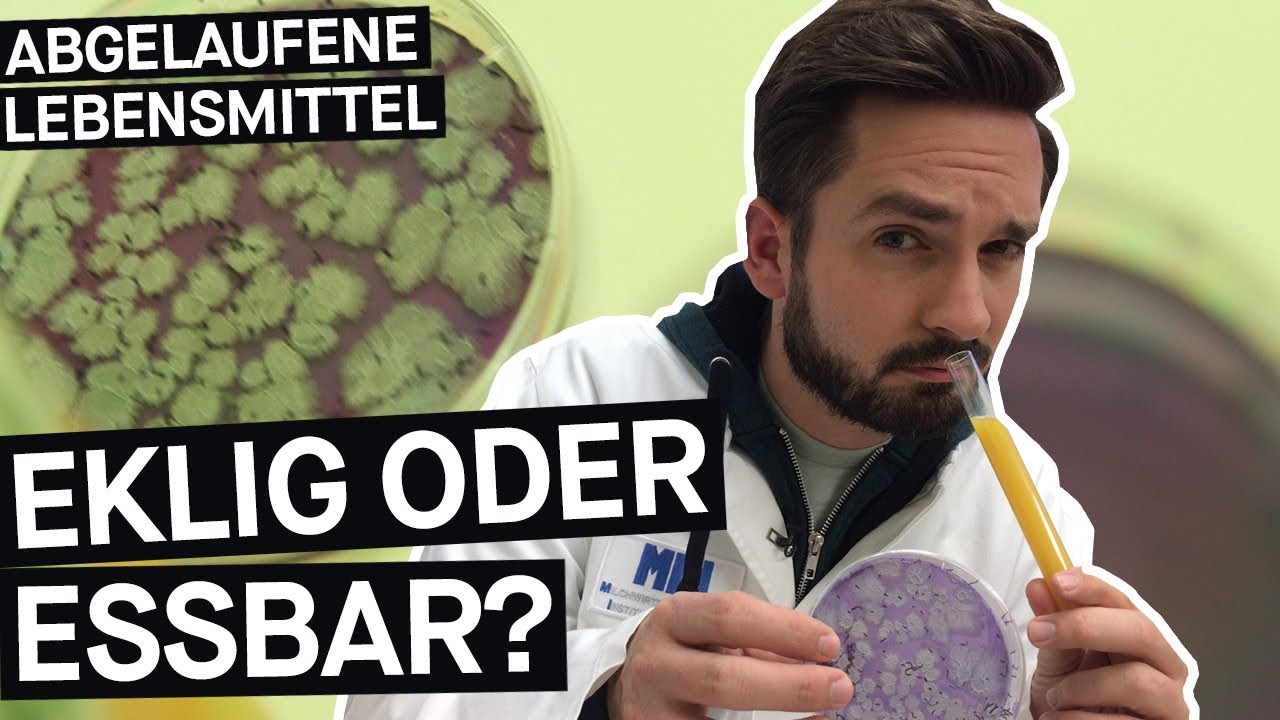
Abgelaufene Lebensmittel: Wie lange sind sie noch genießbar? 🥫

Abgelaufene Lebensmittel: Wie lange sind sie noch genießbar? 🥫
PULS Reportage klärt, ob abgelaufene Lebensmittel noch essbar sind und wie man das richtige Haltbarkeitsdatum interpretiert.

PULS Reportage
1.6M views • Nov 22, 2017
About this video
Sind abgelaufene Lebensmittel noch haltbar? Ist etwas noch essbar, obwohl es das Mindesthaltbarkeitsdatum überschritten hat? Sebastian Meinberg fragt sich für PULS Reportage, was das Mindesthaltbarkeitsdatum taugt und untersucht seinen alten Kühlschrankinhalt im Labor.
Ist das Kunst oder kann das weg?
Jeder kennt sie und hat sie vielleicht sogar selbst: Kühlschrankleichen. Abgelaufenes Pesto oder O-Saft vom letzten Jahr? Bei vielen Leuten landen Lebensmittel mit überschrittenem Mindesthaltbarkeitsdatum sofort in der Tonne. Doch sind sie wirklich schlecht oder ist das Haltbarkeitsdatum nur viel zu knapp gewählt? Wie lange kann man abgelaufene Lebensmittel noch essen und woran erkennt man, ob sie noch gut sind? PULS Reportage-Moderator Sebastian Meinberg probiert selbst aus und sucht Antworten in einem Good Food Store, im Labor und in der Politik.
Das Mindesthaltbarkeitsdatum-Missverständnis:
In Deutschland steht auf Lebensmitteln entweder ein Mindesthaltbarkeitsdatum oder ein Verbrauchsdatum. Das Mindesthaltbarkeitsdatum bedeutet aber nur: Bis zu diesem Datum garantiert der Hersteller die „spezifischen Eigenschaften“ seines Produkts. Danach können sich Geschmack, Geruch, Farbe, Konsistenz und Nährwert verändern. Essen kann man diese vermeintlich „abgelaufenen Lebensmittel“ dann noch lange! Das Verbrauchsdatum steht dagegen auf schnell verderblichen Produkten wie Fisch oder Fleisch. Wenn das Verbrauchsdatum abläuft, gehören Fisch und Fleisch in die Tonne.
Unser Mindesthaltbarkeitsdatum-Tipp:
Bei Fisch und Fleisch solltet ihr euch immer an das Verbrauchsdatum halten, diese Lebensmittel verderben sehr schnell. Wenn bei Produkten aus dem Kühlschrank, wie Joghurt oder Käse, das Mindesthaltbarkeitsdatum überschritten ist, gilt: Genau hinschauen und dran riechen. Wenn’s gut aussieht und normal riecht, ist es unbedenklich essbar. Und keine Sorge: Solltet ihr euch mal irren, bekommt ihr im schlimmsten Falle Durchfall. Alles, was bei Raumtemperatur verkauft wird, kann ewig halten. Diese Lebensmittel könnt ihr auch nach Ablauf des Mindesthaltbarkeitsdatums gut essen.
-----------------------------------------------------------
Hi! Wir sind Ariane Alter und Sebastian Meinberg von PULS, dem jungen Programm des Bayerischen Rundfunks. In unseren Reportagen gehen wir jede Woche spannenden Fragen nach und starten gerne mal Selbstversuche.
Jeden Mittwoch um 15 Uhr gibt’s eine neue Webreportage.
Folge Ariane hinter die Kulissen:
https://instagram.com/namealter/
Erlebe Sebastians Selbstexperimente live:
https://www.instagram.com/heinz.wescher/
-----------------------------
Social Media:
► Facebook: http://www.facebook.com/PULS
► Twitter: http://www.twitter.com/puls_br
► Instagram: http://www.instagram.com/deinpuls
► Snapchat: http://snapchat.com/add/puls_br
►PULS ist das junge Programm des Bayerischen Rundfunks im Radio, Fernsehen & Online. http://deinpuls.de
Schreib uns in die Kommentare, was dich bewegt – wir wagen den Selbsttest und probieren es für dich aus!
Ist das Kunst oder kann das weg?
Jeder kennt sie und hat sie vielleicht sogar selbst: Kühlschrankleichen. Abgelaufenes Pesto oder O-Saft vom letzten Jahr? Bei vielen Leuten landen Lebensmittel mit überschrittenem Mindesthaltbarkeitsdatum sofort in der Tonne. Doch sind sie wirklich schlecht oder ist das Haltbarkeitsdatum nur viel zu knapp gewählt? Wie lange kann man abgelaufene Lebensmittel noch essen und woran erkennt man, ob sie noch gut sind? PULS Reportage-Moderator Sebastian Meinberg probiert selbst aus und sucht Antworten in einem Good Food Store, im Labor und in der Politik.
Das Mindesthaltbarkeitsdatum-Missverständnis:
In Deutschland steht auf Lebensmitteln entweder ein Mindesthaltbarkeitsdatum oder ein Verbrauchsdatum. Das Mindesthaltbarkeitsdatum bedeutet aber nur: Bis zu diesem Datum garantiert der Hersteller die „spezifischen Eigenschaften“ seines Produkts. Danach können sich Geschmack, Geruch, Farbe, Konsistenz und Nährwert verändern. Essen kann man diese vermeintlich „abgelaufenen Lebensmittel“ dann noch lange! Das Verbrauchsdatum steht dagegen auf schnell verderblichen Produkten wie Fisch oder Fleisch. Wenn das Verbrauchsdatum abläuft, gehören Fisch und Fleisch in die Tonne.
Unser Mindesthaltbarkeitsdatum-Tipp:
Bei Fisch und Fleisch solltet ihr euch immer an das Verbrauchsdatum halten, diese Lebensmittel verderben sehr schnell. Wenn bei Produkten aus dem Kühlschrank, wie Joghurt oder Käse, das Mindesthaltbarkeitsdatum überschritten ist, gilt: Genau hinschauen und dran riechen. Wenn’s gut aussieht und normal riecht, ist es unbedenklich essbar. Und keine Sorge: Solltet ihr euch mal irren, bekommt ihr im schlimmsten Falle Durchfall. Alles, was bei Raumtemperatur verkauft wird, kann ewig halten. Diese Lebensmittel könnt ihr auch nach Ablauf des Mindesthaltbarkeitsdatums gut essen.
-----------------------------------------------------------
Hi! Wir sind Ariane Alter und Sebastian Meinberg von PULS, dem jungen Programm des Bayerischen Rundfunks. In unseren Reportagen gehen wir jede Woche spannenden Fragen nach und starten gerne mal Selbstversuche.
Jeden Mittwoch um 15 Uhr gibt’s eine neue Webreportage.
Folge Ariane hinter die Kulissen:
https://instagram.com/namealter/
Erlebe Sebastians Selbstexperimente live:
https://www.instagram.com/heinz.wescher/
-----------------------------
Social Media:
► Facebook: http://www.facebook.com/PULS
► Twitter: http://www.twitter.com/puls_br
► Instagram: http://www.instagram.com/deinpuls
► Snapchat: http://snapchat.com/add/puls_br
►PULS ist das junge Programm des Bayerischen Rundfunks im Radio, Fernsehen & Online. http://deinpuls.de
Schreib uns in die Kommentare, was dich bewegt – wir wagen den Selbsttest und probieren es für dich aus!
Tags and Topics
Browse our collection to discover more content in these categories.
Video Information
Views
1.6M
Likes
21.5K
Duration
16:13
Published
Nov 22, 2017
User Reviews
4.7
(327) Related Trending Topics
LIVE TRENDSRelated trending topics. Click any trend to explore more videos.
Trending Now